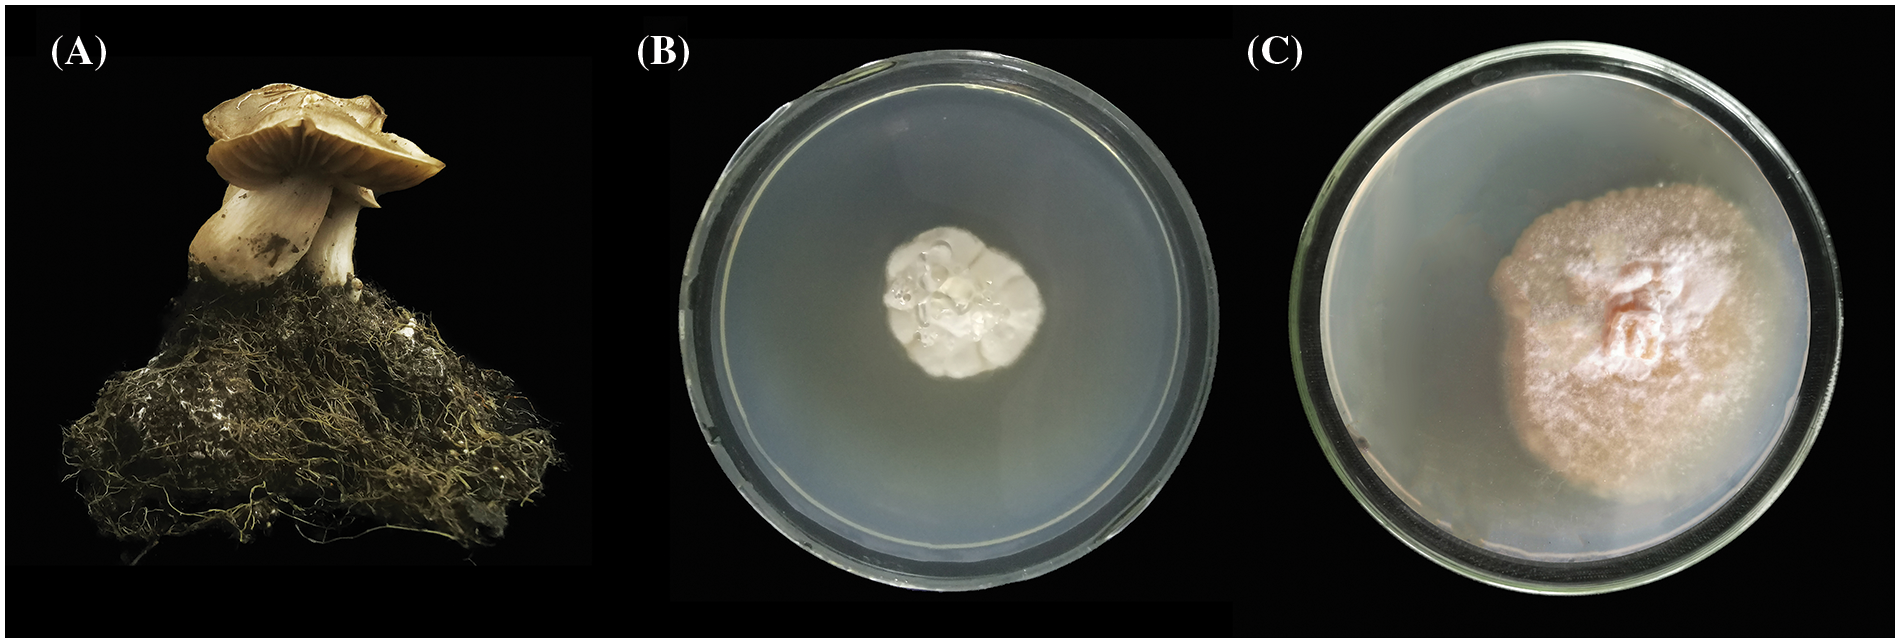
images

Open Access
Open Access
ARTICLE
Mycorrhizal Synthesis and Physiological Responses of Entoloma clypeatum and Three Rosaceae Fruit Trees
School of Agriculture, Ludong University, Yantai, 264000, China
* Corresponding Authors: Jianrui Wang. Email: ; Yu Liu. Email:
Phyton-International Journal of Experimental Botany 2024, 93(12), 3549-3572. https://doi.org/10.32604/phyton.2024.056114
Received 15 July 2024; Accepted 24 September 2024; Issue published 31 December 2024
Abstract
Entoloma clypeatum, a kind of edible ectomycorrhizal fungus, can be usually symbiotic with Rosaceae fruit trees. Fruit trees have become an important part of China’s agriculture. The present work focused on exploring how E. clypeatum affected symbiotic Rosaceae plants and establishing a symbiotic culture with Malus robusta, Pyrus betulifolia and Prunus armeniaca rootstocks. The results showed that E. clypeatum and three Rosaceae plants can generate cylindrical or clavate mycorrhizae. The inoculation treatment had different degrees of positive effects on the three plants. Relative to the non-inoculated group, biomass in symbiotic plants increased (32.8%–191.1%), and photosynthesis enhanced. In the level of plant endogenous hormones, the concentration of zeatin, auxin and gibberellin increased (45.45%–228.95%), and the concentration of abscisic acid decreased (35.99%–76.21%). In roots and leaves of plants, the activities of antioxidant enzymes increased (19.0%–249.8%), soluble sugar, soluble protein and free proline concentrations increased (24.9%–373.3%), and the concentration of malondialdehyde decreased (43.6%–79.1%). According to these findings, E. clypeatum stimulated the growth of M. robusta, P. betulifolia and P. armeniaca and improved stress tolerance and adaptability. Our study provides a basis for developing and applying E. clypeatum, facilitates fruit tree industry development and serves as a resource for studying ectomycorrhizal fungi.Keywords
Ectomycorrhizal fungi (ECMF) are crucial for forest ecosystems [1]. They form ectomycorrhiza in approximately 2% of vascular plants [2]. Additionally, ECMF form epitaxial hyphae, mantles, hating nets, and rhizomorphs on plant root surfaces, which elevates root absorption area, increasing nutrient and deep soil moisture absorption by plants [3]. ECMF dramatically elevates seedling height, biomass, rhizosphere mineral element level, and root length and can promote nutrient release and mineral, increasing plant development [4–6].
Furthermore, ECMF can significantly increase photosynthesis in host plants [7,8]. Gao et al. [9] found that inoculation of Pinus massoniana, Pinus elliottii, and Pinus thunbergii with ECMF, like Pisolithus tinctorius and Boletus speciosus markedly elevated seeding chlorophyll contents. As reported by Chen et al. [10], ECMF inoculation apparently elevated transpiration and net photosynthetic rates in Castanopsis hystrix seedlings. Moreover, ECMF increased protective enzymes activities and osmotically active substance amount within plants. Superoxide dismutase (SOD), catalase (CAT), and peroxidase (POD) represent principal antioxidases in plants [11]. Based on Franco et al. [12], Pisolithus tinctorius and Suillus bellinii increased SOD and CAT activity within the roots and stems in Pinus pinea. According to Chen et al. [13], Pisolithus tinctorius affected SOD, CAT, POD, soluble sugar (SS), free proline (Pro), soluble protein (SP), and malondialdehyde (MDA) levels within symbiotic Quercus acutissima seedlings. When ECMF was symbiotic with Pinus massoniana, osmotically active substances had increased amounts compared with non-mycorrhizal seedlings, while antioxidant enzyme activities were markedly enhanced [14,15].
ECMF can also stimulate increased plant hormone release, including auxin (IAA) and gibberellic acid (GA3) [16]. Fungi can release IAA via auxin transporters, altering endogenous IAA dynamic balance within plants, inhibiting main root development, increasing the lateral root branch number, and facilitating fungal infections [17,18]. During early ectomycorrhizal generation in Laccaria bicolor and Populus tremula, the poplar lateral root number markedly elevated, demonstrating the influence on auxin deposition within plant root tips. Its action mechanisms include PtaPIN9-dependent auxin redistribution and the PtaIAA-mediated auxin signaling pathway. Mycorrhizal fungi increase auxin deposition within plant root tips while promoting lateral root generation [19]. The new lateral root formation can lead to increased mycorrhizal formation [19,20]. In the eighteenth century, Joseph Talon in France transplanted seedlings from truffle-grown oak forests and used these seedlings to establish new parks, and years later, truffles grew in the new parks, inventing the first method of cultivating ectomycorrhizal fungi [21]. Subsequently, researchers optimized Talon’s method by using parent plant technology [22]. In the 21st century, aseptic seedlings have been cultivated using plant tissue culture technology [23], and seedlings have been infected with spore suspensions, fungal broth irrigation or direct contact between plant roots and vigorous mycelia [24]. This method has been the most commonly used method for mycorrhizal synthesis. Some researchers have also isolated the mycelia of ectomycorrhizal fungi by using mycorrhizal root tips; however, there has been interference from many ‘miscellaneous bacteria’, which makes obtaining a pure cultured strain difficult.
Entoloma clypeatum belongs to Basidiomycota, Agaricomycetidae, Agaricales, Entolomataceae, Entoloma [25,26]. The type of ECMF is commonly found in late spring and early summer [26–28]. It generates mycorrhizae with Rosaceae plants, especially pears, apples, and apricots [29,30]. There are few reports on E. clypeatum diversity in China. Szücs and Véghelyi reported that E. clypeatum probably formed ectomycorrhizae in Rosaceae. An investigation of orchards from Hungary revealed that mycorrhizae generation between fruit trees and E. clypeatum was unrelated to soil type. Apricot trees with symbiotic fungi are resistant to water stress and high temperatures, with a 50% reduction in leaf decay, greener leaves, and a 12% increased yield than non-symbiotic apricot trees [31]. Shishikura et al. [25] utilized strains separated from the E. clypeatum complex for infecting pear trees, synthesizing mycorrhizae, and obtaining fruiting bodies.
Shandong Province has one of the most important fruit industries in China. This province has a wide range of fruit tree planting and fruit industry development and is known as the ‘northern deciduous fruit tree kingdom’. Apples, pears, grapes, apricots and other fruits are important part of its planting industry. Among these, apples and pears are the most important fruit tree varieties grown in Shandong Province. The Yantai area is the main production area, and its planting area and yield are among the highest in the country [32]. After nearly three decades of China’s development, the fruit industry has entered a stage of rapid development, with the implementation of dwarf rootstock close planting, eight ridge crabapple, pear and other dominant rootstocks by farmers. This has gradually formed a characteristic industry that has played a positive role in increasing production and income.
During the resource investigation, we found that E. clypeatum was widely distributed in Rosaceae fruit trees and was able to form mycorrhizal symbioses with its roots, especially in orchards cultivating, for example, apples, pears and apricots. Malus robusta, Pyrus betulifolia and Prunus armeniaca are commonly used rootstocks at present; therefore, based on the aforementioned research status, this study is the first time to use E. clypeatum with Malus robusta, Pyrus betulifolia and Prunus armeniaca to synthesize mycorrhiza and measure the biomass and physiological indexes of plants before and after. This research provides a theoretical basis for rational developing and utilizing E. clypeatum while promoting fruit tree industry development.
2.1 Strain Obtaintion and Identification
E. clypeatum was collected from Dadongkuang orchard (121°37’E, 37°50’N), Yantai City, Shandong Province, China. This strain was obtained through performing tissue isolation from the fruiting bodies, cultured with potato dextrose agar (PDA) (consisting of potato 200 g·L−1, agar 16 g·L−1, glucose 20 g·L−1), until the mycelia were covered with plates, and, moved to a new plate to obtain a pure culture.
We isolated fungal genomic DNA in fruiting bodies and mycelia by Ezup Column Fungi Genomic DNA Purification Kit, followed by amplification and sequencing of the internal transcribed spacer (ITS). PCR primers used were ITS1 (5′-TCCGTAGGTGAACCTGCGG-3′) and ITS4 (5′-TCCTCCGCTTATTGATATATGC-3′). The 50 μL PCR system: included 20 μL ddH2O, 25 μL of 2 × SanTaq PCR Mix, 2 μL respective primers (10 μmol/L), and 1 μL DNA (20-30 ng/μL). PCR reaction conditions: 5-min pre-denaturation under 94°C, 30-s under 94°C, 30-s under 52°C, 30-s under 72°C for 35 cycles; 10-min under 72°C and preservation under 4°C. Later, products were subjected to 1% agarose gel electrophores. After the swimming test, samples were sent to the sequencing department at Bioengineering (Shanghai) Co., Ltd. Qingdao for sequencing. We then imported the sequence into GenBank and aligned it using GenBank’s basic local alignment search tool (BLAST). Thereafter, those strains detected were cultivated within modified PDA (potato 200 g·L−1, glucose 25.58 g·L−1, agar 16 g·L−1, peptone 2.52 g·L−1, casein 2.51 g·L−1, KH2PO4 0.15 g·L−1, MgSO4·7H2O 0.05 g·L−1, vitamin B1 0.03 g·L−1, vitamin B2 0.01 g·L−1) for 60-day period under 22°C for obtaining solid strains. The liquid culture was cultured at 130 r·min−1 at 22°C for 14 days in a modified PDA medium without agar.
2.2 Host Seedling Preparations
Malus robusta, Pyrus betulifolia and Prunus armeniaca seeds were selected from Manyuan nursery (117°14′′E, 36°17′′N) of Tai’an county, Shandong Province, China. These three obtained seed species were blended uniformly with moist sand at the 1:3 ratio at 80%–90% humindity, put into the plastic bag, and stored under 4°C for an 80-day period. The contents of the bag were stirred and ventilated at 7-day intervals, and the humidity was measured. After breaking the dormancy of the seeds stored in sand, we cleaned seeds and sew them within vermiculiteat 20°C–25°C, for seed germination. Seed germination was monitored regularly, and water was regularly supplemented. After the production of 2–3 true leaves, 5% sodium hypochlorite solution was added to disinfect seedings prior to transplantation in the sterile cultivation matrix to further culture seedlings.
2.3 Preparation of Solid Inoculation Agar Culture Matrix
The modified PDA solid medium was poured into a canned bottle, 40 mL per bottle, the bottle mouth was sealed with a breathable bottle cap, sterilized at 116°C for 30 min, and cooled and solidified for backup use.
2.4 Preparation of Liquid Inoculation Cultivation Substrate
The peat soil and vermiculite were mixed at 1:2 (v/v) water, placed into the polyethylene bacteria bag, sealed, sterilized at 120°C for 20 min, and cooled for backup use.
2.5 Mycorrhizal Synthesis Method
Solid inoculation culture: Under sterile conditions, the liquid strain of E. clypeatum was inoculated into a canned bottle of medium prepared as described in Section 2.3. Each bottle was inoculated with 5 mL, placed into the 22°C incubator, and cultured in dark till mycelia covered medium surface. The plants seedling surface was wiped with ultrapure water, and the root system was attached to the mycelial surface. The prepared cultivation substrate was covered as in Section 2.4 and placed in a culture room: 22°C, relative air humidity 60%, and a 16 h/8 h photoperiod., The culture room was relatively sterile. Mycorrhizal information was obtained after 90 days of culture.
Liquid inoculation culture: Seeding surfaces were wiped with ultrapure water. After impurities were removed, the seedlings were transplanted into a cultivation matrix prepared as in Section 2.4. Liquid strains of E. clypeatum were inoculated near plant roots. Each plant was inoculated with 10 mL, and placed them in a culture room: 22°C, relative air humidity 60%, and a 16h/8h photoperiod. Mycorrhizal formation was observed after 90 days of culture. The culture room was disinfected before seedlings placement.
2.6 Mycorrhizal and Non-Mycorrhizal Seedling Preparation
Mycorrhizal seedlings: the liquid inoculation culture method in Section 2.5 was used, the plants of this symbiosis system under these conditions were designated as +E.
Non-mycorrhizal seedlings: The preparation method was the same as the liquid inoculation culture method in Section 2.5. When the seedlings were treated with a liquid medium without strains, they were designated as −E.
2.7 Mycorrhizal Infection Rate
We measured the artificial mycorrhizal synthesis rate as described by Phillips et al. [33]. Fifty fine root segments of Malus robusta, Pyrus betulifolia and Prunus armeniaca were chosen at random and prepared in the 1-cm root segments. Mycorrhizal cells number from every root segment was counted microscopically. Mycorrhizal infection rate was calculated by ectomycorrhizal symbiotic root segment number/overall root segment number tested × 100%.
2.8 Mycorrhizal Morphology Analysis
Mycorrhizal morphology was analyzed. To be specific mycorrhiza site was cleaned with ultrapure water, and its macro morphology was observed using a stereoscope.
2.9 Three Plants Physical Index Determination
2.9.1 Growth Index Measurement
Five non-mycorrhizal and five mycorrhizal seedlings of Malus robusta, Pyrus betulaefolia and Prunus armeniaca of the same seedling age were selected, and fresh weight was measured using an electronic balance. The plant height, leaf area (length × width) and ground diameter were determined using a ruler. A vernier caliper was used for measuring the stem diameter. Then, number of leaves was counted.
2.9.2 Determination of Photosynthetic Index
Five non-mycorrhizal and mycorrhizal seedlings of Malus robusta, Pyrus betulaefolia and Prunus armeniaca of the same age were selected. The transpiration rate, photosynthetic rate, intercellular carbon dioxide content and stomatal conductance were analyzed using an LI-6800 new-generation photosynthesis automatic measurement system.
Chlorophyll concentration determination: reference Chance and Maehly’s methods were modified, with five replicates in each group [34]. First, 0.2 g fresh plant leaves and 10 mL 95% ethanol was placed in a mortar, the leaves were ground, and the mixture was filtered in the 25-mL brown volumetric flask. Later 95% ethanol was added to wash both grinding bar and mortar, and the resultant solution was also filtered through a volumetric flask for obtaining the 25 mL constant volume. Absorbance values were read at 665, 649, and 470 nm, with 95% ethanol being adopted to be the blank control. Chlorophyll a, chlorophyll b, and carotenoid concentrations could be determined as follows by Formula (1)–(3).
2.9.3 Determination of Plant Hormone Concentration
Non-mycorrhizal and mycorrhizal seedlings of Malus robusta, Pyrus betulaefolia and Prunus armeniaca of the same seedling age were selected. Each plant was thoroughly cleaned with ultrapure water, and excess water was absorbed using absorbent paper. Zeatin (ZT), IAA, GA3 and abscisic acid (ABA) concentration within plant leaves and roots were determined as described by Tan [21]. The accurate weighing of 2 g samples was achieved with the analytical balance. The samples were sufficiently ground within the mortar after being frozen in liquid nitrogen. Next, after adding 80%, the mixed sample was subjected to 8 h of storage under 4°C.
All pretreated samples for underwent 10 min of centrifugation under 4°C at 8, 000 r·min−1 in a low-temperature centrifuge. Supernatants were obtained into the clean centrifuge tube and preserved under 4°C. Whereas the residual precipitate experienced an additional 2 h of extraction by using 80% methanol aqueous solution, and then 10 min of centrifugation under 4°C at 8, 000 r·min−1. Both supernatants were pooled. Methanol was later removed from supernatants with the nitrogen blow dryer, and the residual liquid was extracted and decolored three times in a separation funnel by using petroleum ether. 1 mol·L−1 citric acid was introduced to adjust solution pH 3 followed by ethyl acetate extraction thrice. All extracts were later pooled, and the ethyl acetate was removed by the same nitrogen blow dryer, dissolved with 1mL methanol and filtered using the 0.22-μm organic filter membrane for later use.
Plant hormone concentration of the aforementioned treated sample was above determined using a high-performance liquid chromatograph (HPLC) under the following conditions: The ZORBAX SB-C18 chromatographic column (4.6 mm, 250 mm, 5 μm; Agilent, Santa Clara, CA, USA) was utilized, with methanol-formic acid gradient elution being the mobile phase. Column temperature, injection volume, and flow rate were 25°C, 20 μL and 1.0 mL·min−1, separately. Detection wavelengths were set at 260 and 220 nm (Table 1).

2.9.4 Determination of Antioxidant Enzyme Activity
Three types of plant mycorrhizal seedlings and non-mycorrhizal root seedlings with the same culture cycle were selected, and washed with ultrapure water. The excess water was absorbed, and weighed with the plant roots and leaves. There were five replicates in each group.
A centrifuge tube was filled with 0.1 g fresh plant root, stem, and leaf samples, they were homogenized with 0.5 mL pre-cooled 0.05 mol·L−1 phosphate buffer (pH 7.8). The homogenate was later added into the 10-mL volumetric flask by using a pipette gun, and stored for a 10-min duration under 4°C. Supernatants were added into the clean centrifuge tube for 15 min of centrifugation at 12,000 r·min−1.
The SOD absorbance was read bynitrogen blue tetrazolium approach at 560 nm, while the SOD activity was calculated (as depicted by Beauchamp et al. [35] after modification) using Formula (4).
The POD was measured using the guaiacol method at 470 nm at 30, 60, 90, and 120 s. The POD activity was calculated (as depicted by Zong et al. [36] after modification) using Formula (5).
The CAT activity was measured using ultraviolet spectrophotometry at 240 nm and 30, 60, 90, and 120 s. Using the enzyme reduction amount per 0.1 within 1 min as an enzyme activity unit. The CAT activity was calculated (as depicted by Chance et al. [34] after modification) using following Formulas (6) and (7):
Ascorbate peroxidase (APX) was measured by using an ascorbate peroxidase kit.
2.9.5 Osmotic Regulatory Substance and Malonaldehyde Concentration Determination
Mycorrhizal and non-mycorrhizal seedlings of Malus robusta, Pyrus betulaefolia and Prunus armeniaca were selected from the same growth cycle. The samples were cleaned with ultrapure water without any interfering impurities. Plant root and leaf samples were harvested, and every treatment was repeated five times.
The Coomassie brilliant blue method of Gao [37], with some modifications was used to measure soluble protein: 0.1 g fresh plant root, stem, and leaf samples were homogenised with distilled water (1-mL). Following repeated washing, samples were added into the 20 mL volumetric flask prior to dilution to 20 mL. Thereafter, this resulting solution underwent 10 min of centrifugation at 3000 r·min−1 to collect supernatants as test solution. Thereafter, 1 mL supernatantwere blended with 5 mL coomassie brilliant blue and incubated for 2 min at 22°C–25°C. Absorbance values were read at 595 nm, with distilled water being the reference. The protein concentration was determined according to the standard curve by using the Formula (8).
The soluble sugar was measured using anthrone colorimetry by Chance et al. [34], with some improvements: 0.1 g fresh plant root, stem, and leaf samples underwent homogenization with 1 mL distilled water. After repeated washing, we added samples into the 10 mL volumetric flask, followed by dilution till 10 mL, 10 min of centrifugation at 10,000 r·min−1, and the resulting supernatant were diluted to 50 mL. The test solution (1 mL) and anthrone (5 mL) were mixed before 10 min of heating within the boiling water bath. After cooling, absorbance values were read at 620 nm, with distilled water as the blank control (9).
The free proline concentration was measured using the acid-ninhydrin chromogenic approach: 0.2 g fresh plant root, stem, and leaf samples were ground into homogenates within the mortar and transferred to the test tube. Next, 3% sulfosalicylic acid (5 mL) was introduced, extracted for a 15-min period within the boiling water bath, cooled till ambient temperature, and filtered. Later, filtrate (2 mL) was mixed with 2 mL glacial acetic acid, and 3 mL 5% acidic ninhydrin thoroughly before 40 min of heating within the boiling water bath. Afterwards, added 5 mL toluene in it and mixed well in the dark for 20 min. The toluene layer was collected to measure the absorbance at 520 nm. Through using distilled water as the control, the proline concentration could be determined according to the standard curve using a modified method by Bates et al. [38], Formula (10).
Malondialdehyde was determined using the thiobarbituric acid method: 0.1 g fresh plant root, stem, and leaf samples were put into the centrifuge tube, 0.5 mL pre-cooled 0.05 mol·L−1 phosphate buffer (pH 7.8) was introduced, mixed well and pipetted into a 10 mL volumetric flask by using a pipette gun. The centrifuge tube was washed repeatedly, and all the filtrate was added into the volumetric flask too to dilute to 10 mL, mixed, and incubated under 4°C for a 10-min duration.
Next, supernatants (2 mL) were mixed with 0.6% thiobarbituric acid (2 mL, TBA) solution and mixed thoroughly before 10 min of boiling within the boiling water bath and 15 min of centrifugation at 4, 000 r·min−1 after cooling. Supernatants were used as the test solution, whereas 0.6% TBA solution as blank control. Absorbance values were read at 532 nm, 600 nm, and 450 nm, and the malondialdehyde concentration was determined (as depicted by Wasowicz et al. [39] after modification) by Formula (11).
Data statistics were performed using Microsoft Excel 2019. Results were represented by means ± standard errors (GraphPad Prism 8.0). One-way ANOVA plus a t-test was performed to analyze significant difference at p < 0.05 (IBM SPSS 19.0). The symbols *, **, *** and **** stand for significant differences at p < 0.05, P < 0.01, p < 0.001 and p < 0.0001, respectively. Associations of parameters such as plant biomass, photosynthetic parameters, plant hormones, antioxidant enzyme activity, osmotic adjustment substance and MDA concentration were analyzed by Pearson correlation analysis (IBM SPSS19.0, ChiPlot).
3.1 Molecular Identification of Strains
After DNA extraction from the fruiting bodies (Fig. 1A) and mycelia (Fig. 1B), PCR amplification was performed to acquire sequence (OR294061, ON819567) was acquired by using PCR amplification, whereas GenBank was applied in BLAST comparison. ITS sequence showed a 100% alignment rate to fruiting body, consistent with results obtained by He et al. [40] (JQ281479). Besides, mycelia had an identical ITS sequence to that of Shishikura et al. [25] (LC533315). Therefore, we concluded that our harvested samples and mycelial isolates were E. clypeatum. In early culture period (Fig. 1B, 2-month culture), the solid strain was dominated by aerial hyphae, while it was predominated by basal hyphae during late-stage culture (Fig. 1C, 8-month culture).
Figure 1: Fruiting body (A) and mycelia (B, C) of E. clypeatum
3.2 Infection Rate and Mycorrhizal Morphology
Measuring the mycorrhizal infection rates of the two infection methods in the three plants, demonstrated that (Fig. 2) the mycorrhizal formation of the three plants by liquid inoculation was higher than that by solid inoculation. Two methods of the same plant showed significant differences. The mycorrhizal infection rates in the solid inoculation culture were 8%–18%, 15%–26% and 8%–15%. The mycorrhizal infection rates in liquid culture were 38%–53%, 50%–66% and 39%–59%. The mycorrhizal infection rates of the liquid inoculation culture were 4.11, 2.88 and 4.18 times higher than those of the solid inoculation culture in Malus robusta, Pyrus betulaefolia and Prunus armeniaca, respectively. Under a stereomicroscope, those generated mycorrhizal roots showed enlargement, clavate or cylindrical shape, silvery-white, and slightly entangled with the hyphae, accompanied by robust and well-developed plant roots (Fig. 3). Un-inoculated seedlings showed no such phenomena. Therefore, artificial E. clypeatum inoculation produced ectomycorrhiza.

Figure 2: Mycorrhizal infection rate of solid inoculation and liquid inoculation. Data are average from 5 replicates (±SEM) under one treatment. “*” stands for a significant difference in an identical tree species between control and treatment groups (“***”, p < 0.001, “****”, p < 0.0001)

Figure 3: Mycorrhizal morphology of different plants. (A) Malus Robusta, (B) Pyrus betulaefolia, (C) Prunus armeniaca. Bar = 2 mm
3.3 Effect of E. clypeatum on the Biomass of Symbiotic Plants
Biomass directly reflects plant growth quality, while E. clypeatum inoculation remarkably enhances seedling development. After inoculation for five months, mycorrhizal seedlings roots showed better development, with denser leaves compared with non-mycorrhizal root seedlings. These results showed that fresh weight, ground diameter, plant height, stem diameter, leaf area and leaf number of Malus robusta mycorrhizal seedlings increased by 191.12%, 46.88%, 133.18%, 82.22%, 151.22% and 130.43% compared with non-mycorrhizal seedlings (p < 0.05). The Pyrus betulaefolia mycorrhizal seedlings were 103.52%, 100.00%, 93.15%, 71.43%, 120.00% and 66.50% higher than the non-mycorrhizal seedlings, respectively. Ground diameter, plant height and leaf number were significantly different (p < 0.05). Compared with those of the mycorrhizal seedlings and non-mycorrhizal seedlings of Prunus armeniaca, the determination indexes were increased by 117.24%, 32.76%, 48.89%, 69.23%, 103.70% and 72.09%, respectively, and mycorrhizal and non-mycorrhizal seedlings were significantly different (p < 0.05). Among the three plants, inoculation promoted plant growth. Additionally, among the three plants, Malus robusta has a greatest effect on fresh weight, plant height, leaf area and leaf number. Fresh weight, leaf area and stem diameter were not significantly affected in Pyrus betulaefolia (Fig. 4).

Figure 4: Roles of E. clypeatum in biomass of Malus robusta, Pyrus betulaefolia and Prunus armeniaca (A) Fresh weight, (B) Ground diameter, (C) Plant height, (D) Stem thick, (E) Leaf number, (F) Leaf area. −E Non-mycorrhizal seedings, +E Mycorrhizal seedlings. Date are average from 5 replicates (±SEM) of each treatment. “*” stands for a significant difference in one tree species between control and treatment groups (“*”, p < 0.05, “**”, p < 0.01, “***”, p < 0.001)
3.4 Effect of E. clypeatum on Photosynthetic Characteristics of Symbiotic Plants
After inoculation with E. clypeatum and symbiotic plants to form mycorrhiza, transpiration rate, net photosynthetic rate, stomatal conductance of symbiotic plants markedly elevated, and the intercellular CO2 concentration decreased (p < 0.05). For Malus robusta mycorrhizal seedlings increased by 188.94%, 126.11% and 104.12%, and decreased by 38.74%, compared with non-mycorrhizal seedlings. The mycorrhizal seedlings increased by 121.44%, 173.73% and 129.22%, and decreased by 30.97%, compared with the Pyrus betulaefolia non-mycorrhizal seedlings. In Prunus armeniaca, increased by 224.37%, 126.62% and 92.45%, and decreased by 37.18%. In the net photosynthetic rate, the effect of mycorrhizal formation on Pyrus betulaefolia was relatively small, and the effect on Prunus armeniaca was more significant than that of the former, however, the increase in stomatal conductance had little significant effect on Prunus armeniaca, and the significant effect on Malus robusta was relatively small for transpiration rate and intercellular CO2 concentration (Fig. 5).

Figure 5: Roles of E. clypeatum in photosynthetic parameters of Malus robusta, Pyrus betulaefolia and Prunus armeniaca (A) Net photosynthetic rate, (B) Transpiration rate, (C) Stomatal conductance, (D) Intercellular concentration of CO2. −E Non-mycorrhizal seedings, +E Mycorrhizal seedlings. Date are average from 5 replicates (±SEM) of each treatment. “*” stands for a significant difference in one tree species between control and treatment groups (“*”, p < 0.05, “**”, p < 0.01, “***”, p < 0.001)
Chlorophyll represents a key pigment used for assessing plant photosynthetic potential. The amount of chlorophyll represents the efficiency of leaf photosynthesis and defines plant growth and development. The chlorophyll concentration in the three plants was determined, in Malus robusta, the concentration of chlorophyll-a and carotenoids in mycorrhizal seedlings increased respectively by 46.34% and 17.35%, compared with that of non-mycorrhizal seedlings. Chlorophyll-b concentration increased by 237.12%, and the difference was of statistical significance (p < 0.05), and chlorophyll a/b ratio declined by 56.59%. Chlorophyll-a, chlorophyll-b and carotenoids concentrations within mycorrhizal and non-mycorrhizal seedlings of Pyrus betulaefolia increased by 130.31%, 145.50% and 59.11%, respectively, and chlorophyll a/b decreased by 6.18%. Differences in chlorophyll-a and chlorophyll-b contents within Prunus armeniaca showed statistical significance between the mycorrhizal and non-mycorrhizal seedlings (p < 0.05), increasing by 116.38% and 136.81%, separately. Carotenoid concentration was not significantly different, which increased by 23.21%, and chlorophyll a/b declined by 8.63%. Among these three plants, effect of mycorrhizal formation on chlorophyll-a concentration was more significant in Prunus armeniaca. Chlorophyll-b concentration within Pyrus betulaefolia was not significantly different. And the increase in carotenoid content was not significant (Fig. 6).

Figure 6: Roles of E. clypeatum in chlorophyll concentration in three plants (A) Malus robusta, (B) Pyrus betulaefolia (C) Pruns armeniaca. −E Non-mycorrhizal seedings, +E Mycorrhizal seedlings. Date are average from 5 replicates (±SEM) of each treatment. “*” stands for a significant difference in one tree species between control and treatment groups (“*”, p < 0.05)
3.5 Effect of E. clypeatum on the Concentration of Symbiotic Plant Hormones
Phytohormones are signaling molecules produced by plant metabolism that can trigger significant physiological responses at very low concentrations. The formation of mycorrhiza between symbiotic plants and E. clypeatum will affect plant hormones concentration. ZT, IAA and GA3 can disrupt dormancy and promote plant growth. In contrast, ABA enhanced plant dormancy, abscission and promoted senescence. Root and leaf hormones levels in the three plant types were measured and compared (Fig. 7). As a result, ZT, GA3 and ABA contents within the roots of the three plants demonstrated significant differences (p < 0.05), and effect on Malus robusta was more significant. Except for Malus robusta, the IAA concentration in the roots of Pyrus betulaefolia and Prunus armeniaca revealed a significant difference (p < 0.05). ZT content in Malus robusta, Pyrus betulaefolia and Prunus armeniaca increased by 186.45%, 192.56% and 165.79%, separately. IAA concentration elevated by 45.45%, 93.30% and 69.8%, separately. GA3 concentration increased by 164.28%, 126.44% and 83.97%, separately. ABA concentrations decreased by 76.21%, 55.98% and 52.31%, separately. Concentrations of four hormones were not significantly different in the leaves of the three plants (p < 0.05). The ZT concentration in the leaves of Malus robusta, Pyrus betulaefolia and Prunus armeniaca increased by 226.18%, 178.85% and 228.95%, respectively. IAA concentration increased by 66.51%, 126.37% and 54.24%, respectively. The concentration of GA3 increased by 66.57%, 92.30% and 88.17%, respectively. ABA concentration decreased by 35.99%, 44.15% and 49.23%, respectively.

Figure 7: Effects of E. on hormone concentration of Malus robusta, Pyrus betulaefolia and Prunus armeniaca (A) ZT concentration, (B) IAA concentration, (C) GA3 concentration, (D) ABA concentration. −E Non-mycorrhizal seedings, +E Mycorrhizal seedlings. Date are average from 5 replicates (±SEM) of each treatment. “*” stands for a significant difference in one tree species between control and treatment groups (“*”, p < 0.05, “**”, p < 0.01)
Interactions between plant hormones also affects the growth of plants. Calculating the ratios of ZT, IAA, GA3 and ABA, demonstrated that mycorrhizal seedlings were improved relative to non-mycorrhizal. For ZT/ABA, the roots and leaves of the three mycorrhizal plants are 6.58, 6.65, 5.57, 5.10, 4.99 and 6.48 times that of the non-mycorrhizal plants. The IAA/ABA rations were 6.11, 4.39, 3.56, 2.60, 4.05 and 3.04 times. GA3/ABA were 11.11, 5.14, 3.85, 2.60, 3.44 and 3.71 times.
3.6 Effect of E. clypeatum on Antioxidase Activities in Symbiotic Plants
The protective enzyme system in plants can work synergistically to effectively reduce potential damage from ROS and additional oxidative free radicals in cell membranes. The activity level of these enzymes is tightly associated with plant resistance to adversity. Measuring SOD, POD, CAT and APX activities in three plants, showed that the formation of mycorrhizal roots promoted antioxida activities (Fig. 8). In Malus robusta and Prunus armeniaca root and leaf samples, SOD activity of inoculated seedlings increased by 25.12%, 92.43%, 26.80% and 122.90% compared with non-inoculated seedlings (p < 0.05). This difference was more significant in Prunus armeniaca mycorrhizal seedlings leaf samples, but roots and leaves in Pyrus betulaefolia mycorrhizal seedlings and non-mycorrhizal seedlings were not significantly different, which increased by 66.42% and 32.97%, respectively. The POD activity demonstrated a significant difference (p < 0.05) except in Malus robusta leaves. The difference in the roots of Pyrus betulaefolia was smaller than that of the other two plants. Root and leaf samples of three plant mycorrhizal seedlings increased by 111.47%, 70.57%, 73.01%, 49.02%, 54.44% and 42.86%, compared with non-mycorrhizal counterparts. In addition to roots in Pyrus betulaefolia, the CAT activities of the leaves of Pyrus betulaefolia, Malus robusta root and leaf samples and Prunus armeniaca root samples were significantly different (p < 0.05). Root and leaf samples in three plants of mycorrhizal seedlings increased by 30.74%, 35.97%, 43.23%, 19.00%, 98.83% and 140.65%, compared with the non-mycorrhizal seedlings. The APX activity was significantly different in root and leaf samples from three plants. Relative to the three plants, the difference of Malus robusta was relatively small (p < 0.05), and their roots and leaves elevated by 105.87%, 232.72%, 228.98%, 119.95%, 110.25% and 249.83%.

Figure 8: Effects of E. clypeatum on antioxidant enzyme activities of Malus robusta, Pyrus betulaefolia and Prunus armeniaca (A) Superoxide dismutase activity, (B) Peroxidase activity, (C) Catalase activity, (D) Ascorbate peroxidase. −E Non-mycorrhizal seedings, +E Mycorrhizal seedlings. Date are average from 5 replicates (±SEM) of each treatment. “*” stands for a significant difference in one tree species between control and treatment groups (“*”, p < 0.05, “**”, p < 0.01)
3.7 Functions of E. clypeatum in Osmotic Adjustment Substances and Malondialdehyde Concentration Within Symbiotic Plants
Plants often accumulate certain soluble substances to ensure that the water balance can be maintained by regulating the osmotic potential energy in the cells, and such substances exert the protection maintaining stability of enzyme activity dependent on many key metabolic reactions in the cells. The inoculation of E. clypeatum in Malus robustum, Pyrus betulaefolia and Prunus armeniaca, had a certain effect on the osmotic adjustment substances in the plants, the concentrations of soluble protein, soluble sugar and free proline increased, and malondialdehyde concentration decreased (Fig. 9). The result shows the significant difference insoluble protein levels within the roots and leaves between mycorrhizal and non-mycorrhizal seedlings (p < 0.05), and the difference in Malus robusta was more significant. The roots and leaf concentration of the three plants increased by 105.87%, 232.72%, 228.98%, 119.95%, 110.25% and 249.83%. The root and leaf soluble sugar concentrations of mycorrhizal seedlings increased by 75.57%, 115.87%, 95.67%, 24.94%, 79.72% and 70.81% compared with non-mycorrhizal counterparts, with the differences were of statistical significance (p < 0.05). The difference between the roots of Pyrus betulaefolia and the leaves of Prunus armeniaca was more obvious. The free proline concentration of the three plants significantly increased (p < 0.05). The difference between the roots and leaves of Malus robusta was greater, which increased by 176.60% and 373.33%, respectively. The roots and leaves of Pyrus betulaefolia and Prunus armeniaca increased by 113.57%, 74.31%, 62.51% and 175.11%. The concentration of malondialdehyde in mycorrhizal seedlings decreased relative to non-mycorrhizal counterparts. The roots of the three plants were significantly different (p < 0.05), which decreased by 43.59%, 56.92% and 56.48%, respectively, and the difference in Pyrus betulaefolia was relatively small. Leaf samples of Malus robusta were not significantly different (49.33%), and leaf samples of Pyrus betulaefolia and Prunus armeniaca were significantly different (p < 0.05), which decreased by 60.74% and 79.11%, respectively.


Figure 9: Effects of E. on osmotic regulatory substance and MDA concentration of Malus robusta, Pyrus betulaefolia and Prunus armeniaca (A) Soluble protein concentration, (B) Soluble sugar concentration, (C) Proline concentration, (D) Malondialdehyde concentration. −E Non-mycorrhizal seedings, +E Mycorrhizal seedlings. Date are average from 5 replicates (±SEM) of each treatment. “*” stands for a significant difference in one tree species between control and treatment groups (“*”, p < 0.05, “**”, p < 0.01)
3.8 Correlation Analysis between Symbiotic Plant Biomass and Each Index
Through the correlation analysis of the biomass indices of symbiotic plants and the correlation between biomass and each measured content showed a positive correlation between the biomass of plants. Net photosynthetic rate, transpiration rate, stomatal conductance, ZT, IAA, GA3, SP, Pro and MDA were positively correlated with plant biomass. The SOD and SS levels were negatively correlated with biomass. Intercellular CO2 concentration showed a positive relation to leaf area whereas negative relation to additional indices. Chlorophyll concentration exhibited a negative relation to ground diameter whereas a positive relation to the biomass of other plants. ABA demonstrated a positive relation to fresh weight, stem diameter and leaf area, but a negative relation to ground diameter, plant height and leaf number. The POD showed a negative relation to stem diameter and leaf area. The CAT exhibited a negative relation to stem diameter and leaf area, but a positive relation to additional indices. APX displayed a positive relation to fresh weight and plant height (Fig. 10).

Figure 10: Correlation analysis between symbiotic plant biomass and each index (A) Plant biomass, (B) Plant biomass and photosynthetic parameters, (C) Plant biomass and plant hormone, (D) Plant biomass and antioxidant enzyme activity, (E) Plant biomass and osmotic adjustment substance and MDA concentration
The present work separated the E. clypeatum mycelia and was the first to symbiotically culture E. clypeatum with Malus robusta, Pyrus betulaefolia and Prunus armeniaca for synthesizing ectomycorrhiza. The ectomycorrhiza morphology was characterized, meanwhile, physicochemical characteristics of mycorrhizal and non-mycorrhizal seedlings post-symbiosis were analyzed.
According to the results of the mycorrhizal infection rate, in the two culture methods of solid inoculation and liquid inoculation, the three seedlings of Malus robusta, Pyrus betulaefolia and Prunus armeniaca formed mycorrhiza with E. clypeatum. The number of mycorrhiza formed by different inoculation methods in the same plant differed, and mycorrhizal infection rate by the same inoculation method in different plants is also different. In these three plants, mycorrhizal infection rate under solid inoculation was 8%–26%, that of liquid inoculation was 38%–66%, and that of liquid inoculation was higher. The low mycorrhizal infection rate of solid inoculation culture may be due to the roots of the plants extending to the bottom of the medium during the growth process, and the hyphae mostly grew on the upper part of the medium, and the contact area between the roots and the hyphae decreased. With prolonged culture time, mycelial activity gradually decreased, and the effect on the roots decreased, resulting in a small number of infections. Additionally, the workload for preparing the agar cultivation matrix is large, and mycelial activity is difficult to unify, which is not conducive to practical production and application. In the liquid inoculation method, the interaction between the root system, mycelia, bacterial liquid and matrix is more conducive to stimulating the response of the root system, and the cost of the liquid mycelia culture method is lower. A bottle of liquid strain can irrigate multiple plant roots, reducing the influence of strain difference on plant mycorrhizal formation, which is conducive to its popularization and application in production.
ECMF remarkably enhances host plant adaptability and positively regulate plant growth [41]. Inoculation with E. clypeatum enhanced the development of Malus robusta, Pyrus betulaefolia and Prunus armeniaca seedlings in terms of ground diameter, plant height, stem diameter, fresh weight, and leaf area. Many epitaxial hyphae developed after the formation of ectomycorrhizal structures. These hyphae can increase the root system effective absorption area, elevating the plant adsorption of nutrients and water from rhizosphere soil via mycelia. Furthermore, they can promote plant development by improving the plant soil environment [42,43].
According to our results, inoculating with E. clypeatum increased total chlorophyll, chlorophyll-a, chlorophyll-b, and carotenoid concentration of the three seedings, conforming to results obtained by Gao et al. [9]. The chlorophyll a/b value represents the plant shade tolerance. A lower ratio represents, better shade tolerance [44]. After inoculation with E. clypeatum, the value of chlorophyll a/b in seedlings decreased, the scattered light utilization rate increased, and leaf photosynthesis time was also increased. As mentioned by Gong et al. [45], ectomycorrhizal fungi inoculation apparently elevated net photosynthetic and transpiration rate of Castanopsis hystrix seedlings. The determination of photosynthetic related indicators, demonstrated that inoculation with E. clypeatum could increase transpiration rate, net photosynthetic rate, and stomatal conductance and reduce intercellular CO2 content in three plants. When the net photosynthetic rate increases, excess CO2 will take part in synthesizing organic matter, leading to reduced CO2 content. The elevated in stomatal conductance increased the CO2 concentration to some extent, which aided organic matter accumulation within the plants.
Plant hormones can modulate root growth, and IAA is especially important [46]. Endogenous hormone accumulation and gradient distribution in root tips, such as IAA, cause mycorrhizal establishment within host plants, thereby modifying their structure [47]. The mycorrhizae formed by fungi and seedlings in this study were clavate or cylindrical, comparable to mycorrhizae formed by symbiosis with wild Rosaceae plants [29]. This differs slightly from wide ellipsoid to fig-shaped, occasionally globose to sub-globose, mycorrhizal symbiosis with pear trees reported in Japan [25]. Mycorrhizae generated under both artificial and field conditions showed no branching, which was the special mycorrhizal properties of Rosaceae plants mediated via hormones or other fungal signals. However, the cause of this phenomenon remains unclear. Fungi that stimulate plant development initially ‘assist’ the plant in constructing the robust root system before absorbing further mineral components in soil [48]. Roots are important sites for ZT synthesis. ZT regulates plant photosynthesis and growth by regulating stomatal opening and closing [49,50]. The changes in GA3 were the same as IAA levels. Following E. clypeatum inoculation, hormone concentration of seedlings elevated with E. clypeatum. GA3 exerts the synergy with IAA, and elevates IAA levels, breaks dormancy, enhances plant development, and inhibits abscission [51]. ABA plays an inhibitory role in plants by accelerating senescence. Plants respond to stress and overcome survival difficulties when their growth rate is high [52]. The ABA concentration in three plants’ seedling roots and leaves decreased significantly after inoculation, with the difference in root concentration being the most significant. Regarding plant hormone interaction, the ratios of ZT/ABA, IAA/ABA and GA3/ABA of post-treatment group after E. clypeatum inoculation increased relative to the non-inoculated control group. An increase in the ZT/ABA ratio can increase chloroplasts activities within leaves and improve photosynthesis. The elevated ratio of IAA to ABA enhances root development and increases nutrient absorption. The ratio of GA3 to ABA increased, which promotes the release of dormancy and enhances the resistance of plants to adverse environments to a certain extent. These results indicate that inoculation with the ECMF influences plant root alterations in plant development. Through altering plant hormones levels within the body, there is a feedback regulation mechanism between the hormones, which act together for ensuring plant growth quality in a direct or indirect manner.
SOD, POD, CAT, and APX, the major plant antioxidases excess free radicals, postpone senescence and keep metabolic balance, and delay senescence. During plant metabolism, SOD as the first-line defense of the plant antioxidant system, converts O2− into H2O2, and controls cell membrane lipid peroxidation, then POD and CAT immediately decompose hydrogen peroxide into harmless water, inhibiting the production of ·OH [53]. The POD can also catalyze the polymerization of phenolic compounds to form lignin, strengthening the cell wall and enhancing resistance [54]. APX exerts a key effect on chloroplasts. It is an important enzyme to remove H2O2 and converts H2O2 into H2O in the ascorbic acid-glutathione cycle. Plant enzymes coordinate with each other, and their activity is a decisive factor in controlling injury, thus better-reflecting plant adaptability to adversity. In this study, four plant enzymes activities were enhanced after inoculation compared with non-inoculated group, suggesting that mycorrhizal fungi improved antioxidant enzyme activities in the seedlings. Antioxidant enzymes protect the integrity of plant cells, keep relative ROS balance, and improve plant ability to resist adversity to a certain extent. The concentration of osmotic adjustment substances in plants is correlated with their stress resistance, and changes in their concentration can reflect the state of the plants and the living environment. According to our results, soluble sugar, soluble protein, and free proline levels remarkably increased in the treatment group compared with control group. Proteins are thought to be abundant in fungal mycelia. Proteins found in fungal secretions during root system infections increase soluble protein levels in plants. Simultaneously, inoculation promoted seedling photosynthesis, which facilitated photosynthetic products productions. Dry matter in plants elevated, thereby elevating osmotically active substances concentrations. Proline regulates permeability and protects the stability of plant cell structures. Because of its metal chelating characteristics, it can be used to be the molecular chaperone, the antioxidant defense molecule for scavenging ROS, activates signals for specific gene functions, restores plants from stress, plays a role of the osmoprotectant, is the candidate source of nitrogen and carbon, and exerts an important effect on plant development [55]. Proline production within plant cells assists in maintaining water absorption, cellular homeostasis, redox balance, and osmotic regulation restoring cell structure while reducing oxidative damage. This provides a good physiological basis for cells to resist adverse external environments and promote plant growth. MDA levels indicate cell membrane injury degree and plant resistance level [56]. Following inoculation, MDA concentration in every part of the plant, including the roots and leaves, decreased, potentially slowing membrane lipid oxidation. Based on these findings, alterations in antioxidase activities and osmotically active substance levels can be good for improving plant stress resistance and environmental adaptability.
Since the symbiotic cultures of mycorrhizal synthesis are only conducted under laboratory-simulated natural conditions, the plant development state mildly differs from that observed in nature, probably resulting in differences between observed and actual results. Thus, researchers should return to the field for further experimental verification. Ectomycorrhizal fungi are necessary for maintaining ecological balance, which have gradually become a critical research topic. However, owing to the wide variety and diversity of fungi and plants, the current research remains in the model hypothesis stage. The interaction mechanism and signal pathway between ectomycorrhizal fungi and symbiotic plants remain unclear, which can only explain the results from the role of the material. However, explaining these phenomena at the molecular level is difficult. The corresponding mycorrhizal seedlings and sterile root seedlings can be analyzed by omics, and the pathways and genes that change at different growth stages can be further clarified, thus, corresponding research should be conducted. Because ectomycorrhizal fungi usually release volatiles to promote the development of symbiotic plants, the secretion of E. clypeatum should can be measured in subsequent studies to explore the mechanism of symbiotic plants and clarify the recognition mechanism of symbiosis establishment.
In this study, mycorrhizal was synthesized using the E. clypeatum and Malus robusta, Pyrus betulaefolia and Prunus armeniaca symbiotic cultures, and their physicochemical indices were analyzed. As a result, inoculation positively affected seedlings. E. clypeatum serves as the effective ectomycorrhizal resource that stimulates seedling development and sets the basis for future rational E. clypeatum resource development. In conclusion, our results lay the theoretical foundation for applying ectomycorrhizal fungi. Additionally, the production of mycorrhizal seedlings of fruit trees might be realized, and the role of ectomycorrhizal fungi in the field can be realized, reducing the use of chemical fertilizers and production costs, increasing production and income and promoting the development of fruit trees.
Acknowledgement: Thanks to all the reviewers who participated in the review.
Funding Statement: This work was provided by the Edible Mushroom Genetic Breeding Innovation Team of the Shandong Agricultural Industry Technology System, grant number SDAIT-07-03, and the Innovation Ability Promotion Project of Sci-Tech SMEs in Shandong Province, grant number 2023TSGC0397.
Author Contributions: The authors confirm contribution to the paper as follows: study conception and design: Yu Liu and Jianrui Wang; data collection: Chunfeng Mu, Xinyan Yu, Xiaoran Chen and Mengmeng Zhu; analysis and interpretation of results: Chen Hao and Chunfeng Mu; draft manuscript preparation: Chen Hao and Yu Liu. All authors reviewed the results and approved the final version of the manuscript.
Availability of Data and Materials: Data are contained within the article.
Ethics Approval: None.
Conflicts of Interest: The authors declare no conflicts of interest to report regarding the present study.
References
1. Dai YC, Yang ZL, Cui BK, Wu G, Yuan HS, Zhou LW, et al. Diversity and systematics of the important macrofungi in Chinese forests. Mycosystema. 2021;40(4):770–805 (In Chinese). doi:10.13346/j.mycosystema.210036. [Google Scholar] [CrossRef]
2. Genre A, Lanfranco L, Perotto S, Bonfante P. Unique and common traits in mycorrhizal symbioses. Nat Rev Microbiol. 2020;18(11):649–60. doi:10.1038/s41579-020-0402-3. [Google Scholar] [CrossRef]
3. Liu Y, Li X, Kou Y. Ectomycorrhizal fungi: participation in nutrient turnover and community assembly pattern in forest ecosystems. Forests. 2020;11(4):453. doi:10.3390/f11040453. [Google Scholar] [CrossRef]
4. Segnitz RM, Russo SE, Davies SJ, Peay KG. Ectomycorrhizal fungi drive positive phylogenetic plant-soil feedbacks in a regionally dominant tropical plant family. Ecology. 2020;101(8):e03083. doi:10.1002/ecy.3083. [Google Scholar] [CrossRef]
5. Luciano A, Vetúria LO, Germano NSF. Utilization of rocks and ectomycorrhizal fungi to promote growth of eucalypt. Braz J Microbiol. 2020;41(3):676–84. doi:10.1590/S1517-83822010000300018. [Google Scholar] [PubMed] [CrossRef]
6. Smits MM, Bonneville S, Benning LG, Banwart SA, Leake JR. Plant-driven weathering of apatite: the role of an ectomycorrhizal fungus. Geobiology. 2012;10(5):445–56. doi:10.1111/j.1472-4669.2012.00331.x. [Google Scholar] [PubMed] [CrossRef]
7. Zhang Y, Zhong CL, Chen Y, Chen Z, Jiang QB, Wu C, et al. Improving drought tolerance of Causarina equisetifolia seedlings by arbuscular mycorrhizas under glasshouse conditions. New Forests. 2010;40(3):261–71. doi:10.1007/s11056-010-9198-8. [Google Scholar] [CrossRef]
8. Fu R, Guo SJ, Ma LY. The morphology and physiological response of mycorrhizal seedlings of Quercus variabilis under different soil moisture levels. J Northwest Forest University. 2011;26(2):101–104+206 (In Chinese). [Google Scholar]
9. Gao Y, Wu XQ. Effects of several ectomycorrhizal fungi on the chlorophyll content and chlorophyll fluorescence parameters in different pine seedlings. J Nanjing Forest Univ (Nat Sci Ed). 2010;34(6):9–12 (In Chinese). doi:10.3969/j.jssn.1000-2006.2010.06.003. [Google Scholar] [CrossRef]
10. Chen YL, Gong MQ, Chen Y, Wang FZ. Effects of inoculation with 11 ectomycorrhizal fungal isolates on growth and photosynthesis of Castanopsis hystrix saplings. Forest Res. 2001;5:515–22. [Google Scholar]
11. He JL, Qin JJ, Long LY, Ma YL, Li H, Li K, et al. Net cadmium flux and accumulation reveal tissue-specific oxidative stress and detoxification in Populus × canescens. Physiologia Plantarum. 2011;143(1):50–63. doi:10.1111/j.1399-3054.2011.01487.x. [Google Scholar] [CrossRef]
12. Franco AR, Pereira SI, Castro PM. Effect of benfluralin on Pinus pinea seedlings mycorrhized with Pisolithus tinctorius and Suillus bellinii—study of plant antioxidant response. Chemosphere. 2014;120:422–30. doi:10.1016/j.chemosphere.2014.08.019. [Google Scholar] [PubMed] [CrossRef]
13. Chen JM, Liu CY, Chen C, Wu C. Effects of pisolithus tinctorius colonization on the drought tolerance of Quercus acutissima seedlings. J Central South Univ Forest Technol. 2023;43(5):36–48 (In Chinese). doi:10.14067/j.cnki.1673-923x.2023.05.005. [Google Scholar] [CrossRef]
14. Yin DC, Deng X, Ilan C, Song RQ. Physiological responses of Pinus sylvestris var. mongolica seedlings to the interaction between Suillus grevillei N40 and Trichoderma virens T43. Chin. J Ecol. 2014;3(08):2142–7. doi:10.13292/j.1000-4890.2014.0199. [Google Scholar] [CrossRef]
15. Gao XL, Zhang LZ, Tang Y, Zou F, Xiong H, Zhu JL, et al. Effects of ectomycorrhizal fungi inoculation on the growth and physiological characteristics of Quercus variabilis from different provenances. J Central South Univ Forest Technol. 2022;42(11):63–70 (In Chinese). doi:10.14067/j.cnki.1673-923x.2022.11.007. [Google Scholar] [CrossRef]
16. Morrison EN, Knowles S, Hayward A, Thorn RG, Saville B, Emery RJ. Detection of phytohormones in temperate forest fungi predicts consistent abscisic acid production and a common pathway for cytokinin biosynthesis. Mycologia. 2015;107(2):667–92. doi:10.3852/14-157. [Google Scholar] [PubMed] [CrossRef]
17. Raudaskoski M, Kothe E. Novel findings on the role of signal exchange in arbuscular and ectomycorrhizal symbioses. Mycorrhiza. 2015;25(4):243–52. doi:10.1007/s00572-014-0607-2. [Google Scholar] [PubMed] [CrossRef]
18. Tan Q, You L, Hao C, Wang J, Liu Y. Effects of four bolete species on ectomycorrhizae formation and development in Pinus thunbergii and Quercus acutissima. BMC Ecol Evo. 2024;24(1):54. doi:10.1186/s12862-024-02239-w. [Google Scholar] [PubMed] [CrossRef]
19. Felten J, Kohler A, Morin E, Bhalerao RP, Palme K, Martin F, et al. The ectomycorrhizal fungus Laccaria bicolor stimulates lateral root formation in Poplar and Arabidopsis through auxin transport and signaling. Plant Physiol. 2009;151(4):1991–2005. doi:10.1104/pp.109.147231. [Google Scholar] [PubMed] [CrossRef]
20. Feng W, Sun X, Ding G. Morphological and transcriptional characteristics of the symbiotic interaction between Pinus massoniana and Suillus bovinus. J Fungi. 2022;8(11):1162. doi:10.3390/jof8111162. [Google Scholar] [PubMed] [CrossRef]
21. Tan QW. Study on culture characteristics of 4 kinds of Boleti and physiological characteristics of their ectomycorrhizal seedings (Master’s Thesis). University of Ludong: Yantai, China; 2023 (In Chinese). [Google Scholar]
22. Giovannetti G, Roth-Bejerano N, Zanini E, Kagan-Zur V. Truffles and their cultivation. Horticultural Reviews. 1994;16:71–107. doi:10.1002/9780470650561.ch3. [Google Scholar] [CrossRef]
23. Outekrabt A, Chevalier G, Pargney JC, Dexheimer J. Mycorrhization by Tuber melanosporum Vitt. of vitroplants of Quercus robur L. and Quercus pubescens wild. Agronomie. 1990;2(10):127–32. doi:10.1051/AGRO:19900205. [Google Scholar] [CrossRef]
24. Hall IR, Wang Y, Danell E, Zambonelli A. Edible mycorrhizal mushrooms and their cultivation. In: Proceedings of the Second International Conference on Edible Mycorrhizal Mushrooms, 2022 Jul 3–6; Christchurch, New Zealand. [Google Scholar]
25. Shishikur M, Takemura Y, Sotome K, Maekawa N, Nakagirl A, Endo N. Four mycelial strains of Entoloma clypeatum species complex form ectomycorrhiza-like roots with Pyrus betulifolia seedlings in vitro, and one develops fruiting bodies 2 months after inoculation. Mycorrhiza. 2021;31(1):31–42. doi:10.1007/s00572-020-00994-4. [Google Scholar] [PubMed] [CrossRef]
26. Noordeloos ME. Entoloma subgenera Entoloma and Allocybe in the Netherlands and adjacent regions with a reconnaissance of their remaining taxa in Europe. Persoonia. 1981;11(2):153–256. [Google Scholar]
27. Kobayashi H, Dwgawa Y, Yamada A. Two new records of entolomatoid fungi associated with rosaceous plants from Japan. Mycoscience. 2003;44(4):331–3. doi:10.1007/S10267-003-0111-6. [Google Scholar] [CrossRef]
28. Li CH, Deng WQ, Song B, Li TH, Shen YH, Yang WD. Known species of Entolomataecae from China and its taxonomic issues. J Fungal Res. 2008;(3):137–54 (In Chinese). doi:10.13341/j.jfr.2008.03.005. [Google Scholar] [CrossRef]
29. Kobayashi H, Hatana K. A morphological study of the mycorrhiza of Entoloma clypeatum f. hybridum on Rosa multiflora. Mycoscience. 2001;42(1):83–90. doi:10.1007/BF0246397. [Google Scholar] [CrossRef]
30. He XL. Taxonomy of Entoloma in China and molecular phylogeny on Entolomataceae (Ph.D. Thesis). South China Agricultural University: China; 2012 (In Chinese). [Google Scholar]
31. Szücs E, Véghelyi K. Observation with Entoloma clypeatum mycorrhizal fungus in Hungarin orchards. Acta Hortic. 1998;477:123–6. doi:10.17660/ActaHortic.1998.477.15. [Google Scholar] [CrossRef]
32. Gao WS, Li GD, Wang ZG, Li ML, Cui XF, Yu GH. The development course, achievement and prospect of fruit industry in Shandong Province in one hundred years. Deciduous Fruits. 2021;53(4):1–5 (In Chinese). doi:10.13855/j.cnki.lygs.2021.04.001. [Google Scholar] [CrossRef]
33. Phillips JM, Hayman DS. Improved procedures for clearing roots and staining parasitic and vesicular-arbuscular mycorrhizal fungi for rapid assessment of infection. Trans British Mycol Soc. 1970;55(1):158–61. doi:10.1016/S0007-1536(70)80110-3. [Google Scholar] [CrossRef]
34. Chance B, Maehly AC. Assay of catalase and peroxidase. Methods Enzymol. 1955;2:764–75. [Google Scholar]
35. Beauchamp C, Fridovich I. Superoxide dismutase: improved assays and an assay applicable to acrylamide gels. Anal Biochem. 1971;44(1):276–87. doi:10.1016/0003-2697(71)90370-8. [Google Scholar] [PubMed] [CrossRef]
36. Zong XF, Wang SG. Plant physiology research techniques. Chongqing, China: Southwest Normal University Press; 2011 (In Chinese). [Google Scholar]
37. Gao JF. Experimental supervision of plant physiology. Beijing, China: Higher Education Press; 2006 (In Chinese). [Google Scholar]
38. Bates LS, Waldren RP, Teare LD. Rapid determination of free proline for water-stress studies. Plant Soil. 1973;39:205–7. doi: 10.1007/BF00018060. [Google Scholar] [CrossRef]
39. Wasowicz W, Jean N, Peratz A. Optimized steps in fluorometric determination of thiobarbituric acid reactive substances in serum; importance of extraction pH and influence of sample preservation and storage. Clin Chem. 1993;38(12):2522–6. doi:10.1093/clinchem/39.12.2522. [Google Scholar] [CrossRef]
40. He XL, Li TH, Jiang ZD, Shen YH. Four new species of Entoloma s.l. (Agaricales) from southern China. Mycol Prog. 2012;11(4):915–25. doi:10.1007/s11557-012-0807-0. [Google Scholar] [CrossRef]
41. Wu RTGS, Wang J, Zhao RG, Su LGW. Research advances in ectomycorrhizal ecology. J Anhui Agric Sci. 2018;46(6):26–28+36 (In Chinese). doi:10.13989/j.cnki.0517-6611.2018.06.007. [Google Scholar] [CrossRef]
42. Sato T, Hachiya S, Inamura N, Ezawa T, Cheng W, Tawaraya K. Secretion of acid phosphatase from extraradical hyphae of the arbuscular mycorrhizal fungus Rhizophagus clarus is regulated in response to phosphate availability. Mycorrhiza. 2019;29:599–605. doi:10.1007/s00572-019-00923-0. [Google Scholar] [PubMed] [CrossRef]
43. Liu D. Managing both internal and foreign affairs-a PHR-centered gene network regulates plant-mycorrhizal symbiosis. Chin Bull Bot. 2021;56(6):1–4 (In Chinese). doi:10.11983/CBB21177. [Google Scholar] [CrossRef]
44. Qiu Y, Chen JH, Wang LF, Fan P, Sun YK, Wu GH. Study on shade tolerance of different Osmanthus fragrans varieties. J Zhejiang Agric Sci. 2016;57(4):534–7 (In Chinese) doi:10.16178/j.issn.0528-9017.20160426. [Google Scholar] [CrossRef]
45. Gong MQ, Chen YL, Zhong CL. Mycorrhizal research and application. Beijing: China Forestry Publishing House; 1997 (In Chinese). [Google Scholar]
46. Li MZ. Functions and molecular mechanisms of SAUR15 in regulating development of plant lateral and adventitious roots (Ph.D. Thesis). Lanzhou University: China; 2022 (In Chinese). [Google Scholar]
47. Xiong H. Study on ectomycorrhizal effect and symbiosis mechanism of Castanea henryi (Master’s Thesis). Central South University of Forestry & Technology: China; 2019 (In Chinese). [Google Scholar]
48. Yin DC, Saiyaremu HF, Song RQ, Qi JY, Deng X, Deng JF. Efects of an ectomycorrhizal fungus on the growth and physiology of Pinus sylvestris var. mongolica seedlings subjected to saline-alkali stress. J Forestr Res. 2020;31(3):781–8. doi:10.1007/s11676-019-01007-7. [Google Scholar] [CrossRef]
49. Silva‐Navas J, Conesa CM, Saez A, Navarro‐Neila S, Garcia‐Mina JM, Zamarreño AM, et al. Role of cis-zeatin in root responses to phosphate starvation. New Phytologist. 2019;224(1):242–57. doi:10.1111/nph.16020. [Google Scholar] [PubMed] [CrossRef]
50. Zhou YF, Wang DQ, Lu ZB. Effects of drought stress on photosynthetic characteristics and endogenous hormone ABA and CTK contents in green-stayed sorghum. Scientia Agricultura Sinica. 2014;47(4):655–63 (In Chinese). doi:10.1080/15592324.2023.2215025. [Google Scholar] [PubMed] [CrossRef]
51. Petricka JJ, Winter CM, Benfey PN. Control of Arabidopsis root development. Annu Rev Plant Biol. 2012;63(1):563–90. doi:10.1146/annurev-arplant-042811-105501. [Google Scholar] [PubMed] [CrossRef]
52. Ahmad N, Jiang Z, Zhang L, Hussain I, Yang X. Insights on Phytohormonal crosstalk in plant response to nitrogen stress: a focus on plant root growth and development. Int J Mol Sci. 2023;24(4):3631. doi:10.3390/ijms24043631. [Google Scholar] [PubMed] [CrossRef]
53. Qi JY, Deng JF, Yin DC, Cai LX, Liu DP, Zhang LL, et al. Effects of inoculation of exogenous mycorrhizal fungi on the antioxidant configuration enzyme activity of Pinus tabulaeformis seedlings. Acta Ecolosica Sinica. 2019;39(8):2826–32 (In Chinese). doi:10.5846/stxb201805091027. [Google Scholar] [CrossRef]
54. Chen XY. Effect of arbuscular mycorrhizal fungi and interplanted of pokeweed on potassium absorbtionand physiological metabolism of kiwifruit (Master’s Thesis). Southwest University: Chongqing, China; 2016 (In Chinese). [Google Scholar]
55. Ghosh UK, Islam MN, Siddiqui MN, Cao X, Khan MAR. Proline, a multifaceted signalling molecule in plant responses to abiotic stress: understanding the physiological mechanisms. Plant Biol. 2022;24(2):227–39. doi:10.1111/plb.13363. [Google Scholar] [PubMed] [CrossRef]
56. Azarabadi S, Abdollahi H, Torabi M, Salehi Z, Nasiri J. ROS generation, oxidative burst and dynamic expression profiles of ROS-scavenging enzymes of superoxide dismutase (SODcatalase (CAT) and ascorbate peroxidase (APX) in response to Erwinia amylovora in pear (Pyrus communis L). Eur J Plant Pathol. 2016;147(2):279–94. doi:10.1007/s10658-016-1000-0. [Google Scholar] [CrossRef]
Cite This Article
 Copyright © 2024 The Author(s). Published by Tech Science Press.
Copyright © 2024 The Author(s). Published by Tech Science Press.This work is licensed under a Creative Commons Attribution 4.0 International License , which permits unrestricted use, distribution, and reproduction in any medium, provided the original work is properly cited.


 Submit a Paper
Submit a Paper Propose a Special lssue
Propose a Special lssue View Full Text
View Full Text Download PDF
Download PDF Downloads
Downloads
 Citation Tools
Citation Tools